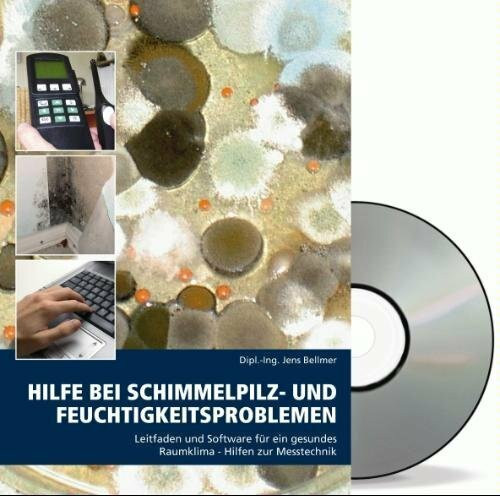
Hilfe bei Schimmelpilz- und Feuchtigkeitsproblemen: Leitfaden und Software für ein gesundes Raumklima, ergiebige Hilfen zur Messtechnik

Hilfe bei Schimmelpilz- und Feuchtigkeitsproblemen: Leitfaden und Software für ein gesundes Raumklima, ergiebige Hilfen zur Messtechnik
Kurzinformation
inkl. MwSt. Versandinformationen
Lieferzeit 1-3 Werktage
Lieferzeit 1-3 Werktage

Beschreibung
Das Buch "Hilfe bei Schimmelpilz- und Feuchtigkeitsproblemen: Leitfaden und Software für ein gesundes Raumklima" von Jens Bellmer bietet umfassende Informationen zur Prävention und Bekämpfung von Schimmelpilzbefall und Feuchtigkeitsproblemen in Innenräumen. Es richtet sich an Hausbesitzer, Mieter und Fachleute, die ein gesundes Raumklima sicherstellen möchten. Der Leitfaden erklärt die Ursachen von Feuchtigkeitsschäden und gibt praktische Tipps zur Vorbeugung und Sanierung. Zudem werden moderne Messtechniken vorgestellt, um Feuchtigkeit effektiv zu erkennen und zu kontrollieren. Begleitend zum Buch bietet eine Software zusätzliche Unterstützung bei der Analyse und Lösung dieser Probleme.
Produktdetails

So garantieren wir Dir zu jeder Zeit Premiumqualität.
Über den Autor

- Kartoniert
- 185 Seiten
- Erschienen 2016
- VDE VERLAG GmbH

- paperback
- 356 Seiten
- Biophanie

- hardcover
- 584 Seiten
- Hüthig Jehle Rehm

- hardcover
- 480 Seiten
- Erschienen 1988
- Hüthig Jehle Rehm

- perfect -
- -

- Kartoniert
- 489 Seiten
- Erschienen 2013
- UTB





































